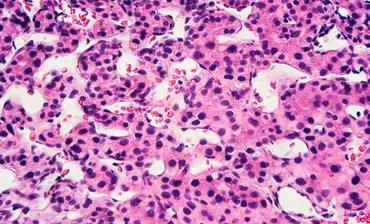
Hepatitis virus particles, TEM. © Science Photo Library

Hepatitis E
Hepatitis E is an acute or chronic infection with the hepatitis E virus (HEV). In Europe, most of the infections are locally-acquired and asymptomatic. Acute infections cause a self-limiting hepatitis, but can become chronic in immuno-compromised patients with the risk of the development of severe liver cirrhosis. HEV has also been described related to other clinical syndromes e.g. neurological.
